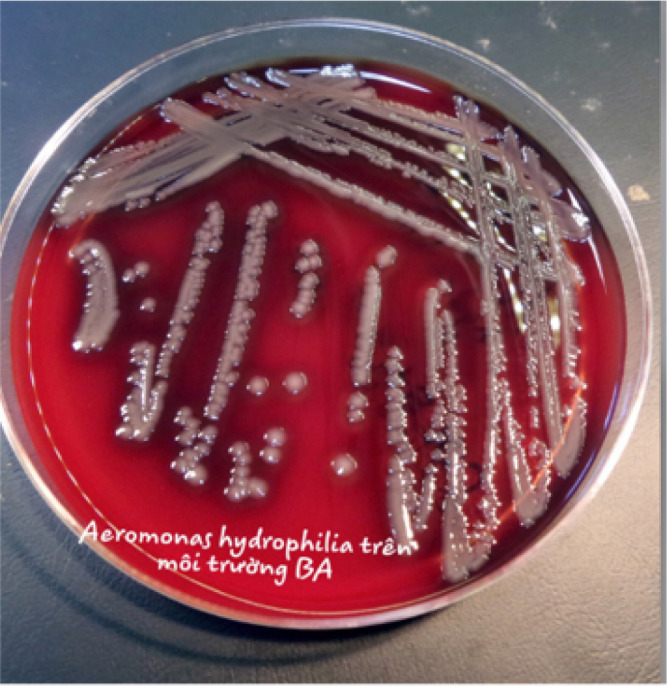

Fatal Septic Shock Due to Aeromonas Hydrophila in a Cirrhotic Patient; a Case Report.
IF 2
Q1 EMERGENCY MEDICINE
Archives of Academic Emergency Medicine
Pub Date : 2024-03-15
eCollection Date: 2024-01-01
DOI:10.22037/aaem.v12i1.2270
引用次数: 0
Abstract
Aeromonas hydrophila has been identified as a causative agent of necrotizing fasciitis and myonecrosis, with most reported cases having a connection to aquatic-related trauma. Cases without such trauma history are rare in existing literature. Here, we present the case of a 56-year-old cirrhotic patient who lacked any prior aquatic-related trauma and arrived at the emergency department in a state of septic shock. The suspected route of entry was through necrotizing fasciitis and myonecrosis in his left forearm. Unfortunately, the patient succumbed to multi-organ failure and passed away within 12 hours of admission to the emergency department.

肝硬化患者因嗜水气单胞菌引发致命性脓毒性休克;病例报告。
嗜水气单胞菌已被确定为坏死性筋膜炎和肌坏死的致病菌,大多数报道的病例都与水生创伤有关。在现有文献中,没有此类外伤史的病例很少见。在此,我们介绍了一例 56 岁的肝硬化患者的病例,该患者之前没有任何与水有关的外伤,到达急诊科时处于脓毒性休克状态。疑似感染途径是左前臂坏死性筋膜炎和肌坏死。不幸的是,患者在急诊科入院后12小时内因多器官功能衰竭而去世。
本文章由计算机程序翻译,如有差异,请以英文原文为准。
求助全文
约1分钟内获得全文
求助全文
来源期刊

Archives of Academic Emergency Medicine
Medicine-Emergency Medicine
CiteScore
8.90
自引率
7.40%
发文量
0
审稿时长
6 weeks
 求助内容:
求助内容: 应助结果提醒方式:
应助结果提醒方式:


